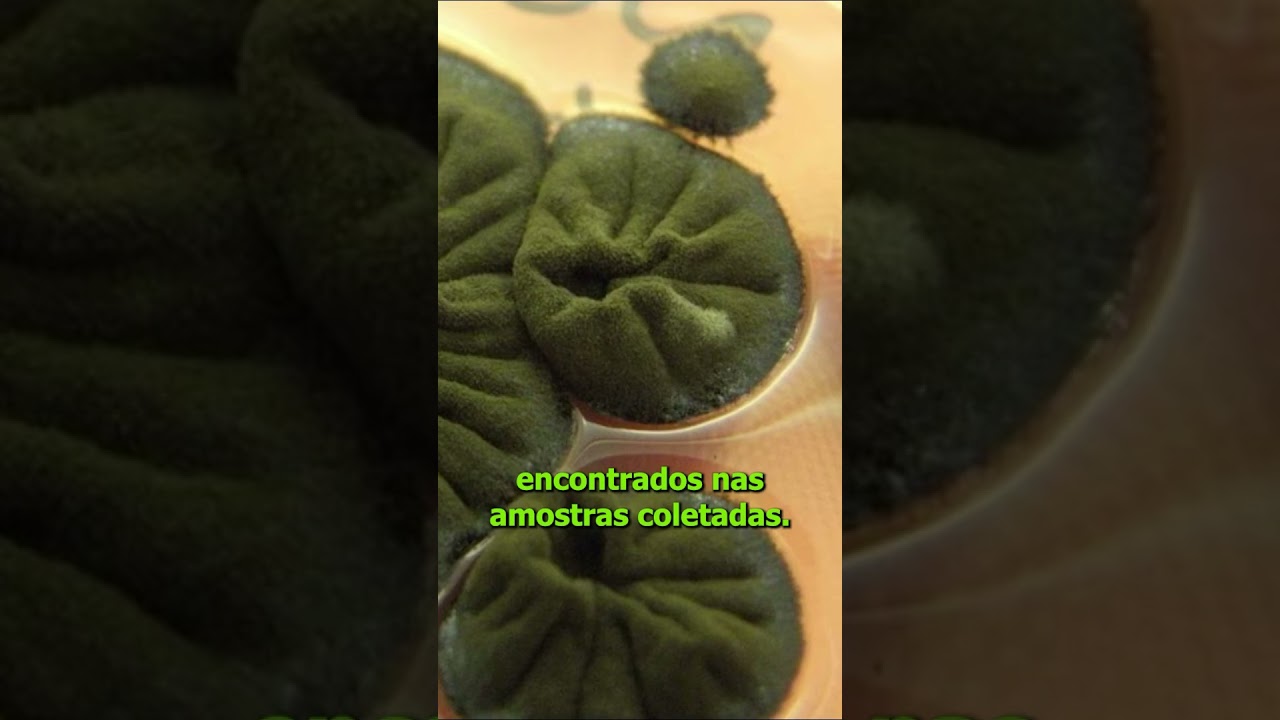
Fungos de Chernobyl intrigam cientistas ao crescer com radiação

Posts Similares

Amazon Prime Video: lançamentos da semana (27 de novembro a 3 de dezembro)
Marcelo adin e Eddie Murphy são os Destaques da semana do amazon Prime Vídeo Os assinantes terão também vão Contar Aliás com a estreia de uma nova Série de suspense sul-coreana vamos dar Uma Olhada um dos grandes destaques do…

Empresas investem em tecnologia para ler a mente dos funcionários
E Olhem só essa história é uma Tecnologia que permite de certa maneira Que os patrões acessem os padrões Mentais dos funcionários para os Criadores da novidade trata-se de uma Maneira de ajudar os profissionais a Tomar decisões mais rápidas…

China anuncia primeira missão de coleta de amostras do lado oculto da Lua
E a administração espacial Nacional da China anunciou a primeira missão de Coleta de amostras no chamado lado Oculto da lua essa Conquista nunca foi Alcançada por país nenhum do mundo e Deve acontecer muito em breve vamos Conferir Em…

Russos e americanos devem continuar lançamentos em conjunto para o espaço até 2025
Uma importante cooperação espacial está Ganhando mais fôlego mesmo em meio às Tensões geopolíticas por aqui na Superfície Rússia e Estados Unidos Estenderam os trabalhos de missões Conjuntas a estação espacial Internacional até 2025 essa parceria tem Sido um grande…


